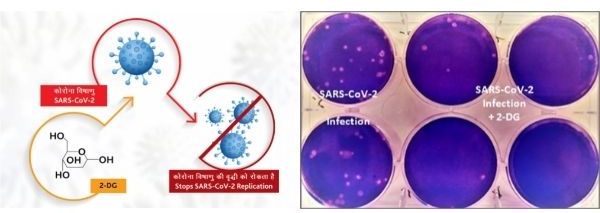

TBB BUREAU
NEW DELHI, MAY 8, 2021
An anti-COVID-19 therapeutic application of the drug 2-deoxy-D-glucose (2-DG) has been developed by Institute of Nuclear Medicine and Allied Sciences (INMAS), a lab of Defence Research and Development Organisation (DRDO), in collaboration with Dr Reddy’s Laboratories (DRL), Hyderabad. Clinical trial results have shown that this molecule helps in faster recovery of hospitalised patients and reduces supplemental oxygen dependence. Higher proportion of patients treated with 2-DG showed RT-PCR negative conversion in COVID patients. The drug will be of immense benefit to the people suffering from COVID-19.
Pursuing Prime Minister Narendra Modi’s call for preparedness against the pandemic, DRDO took the initiative of developing anti-COVID therapeutic application of 2-DG. In April 2020, during the first wave of the pandemic, INMAS-DRDO scientists conducted laboratory experiments with the help of Centre for Cellular and Molecular Biology (CCMB), Hyderabad and found that this molecule works effectively against SARS-CoV-2 virus and inhibits the viral growth. Based on these results, Drugs Controller General of India’s (DCGI) Central Drugs Standard Control Organization (CDSCO) permitted Phase-II clinical trial of 2-DG in COVID-19 patients in May 2020.

The DRDO, along with its industry partner DRL, Hyderabad, started the clinical trials to test the safety and efficacy of the drug in COVID-19 patients. In Phase-II trials (including dose ranging) conducted during May to October 2020, the drug was found to be safe in COVID-19 patients and showed significant improvement in their recovery. Phase IIa was conducted in six hospitals and Phase IIb (dose ranging) clinical trial was conducted at 11 hospitals all over the country. Phase-II trial was conducted on 110 patients.
In efficacy trends, the patients treated with 2-DG showed faster symptomatic cure than Standard of Care (SoC) on various endpoints. A significantly favourable trend (2.5 days difference) was seen in terms of the median time to achieving normalisation of specific vital signs parameters when compared to SoC.
Based on successful results, DCGI further permitted the Phase-III clinical trials in November 2020. The Phase-III clinical trial was conducted on 220 patients between December 2020 to March 2021 at 27 COVID hospitals in Delhi, Uttar Pradesh, West Bengal, Gujarat, Rajasthan, Maharashtra, Andhra Pradesh, Telangana, Karnataka and Tamil Nadu. The detailed data of phase-III clinical trial was presented to DCGI. In 2-DG arm, significantly higher proportion of patients improved symptomatically and became free from supplemental oxygen dependence (42% vs 31%) by Day-3 in comparison to SoC, indicating an early relief from Oxygen therapy/dependence.
The similar trend was observed in patients aged more than 65 years. On May 01, 2021, DCGI granted permission for Emergency Use of this drug as adjunct therapy in moderate to severe COVID-19 patients. Being a generic molecule and analogue of glucose, it can be easily produced and made available in plenty in the country.
The drug comes in powder form in sachet, which is taken orally by dissolving it in water. It accumulates in the virus infected cells and prevents virus growth by stopping viral synthesis and energy production. Its selective accumulation in virally infected cells makes this drug unique.
In the ongoing second COVID-19 wave, a large number of patients are facing severe oxygen dependency and need hospitalisation. The drug is expected to save precious lives due to the mechanism of operation of the drug in infected cells. This also reduces the hospital stay of COVID-19 patients.
 The Business Bytes
The Business Bytes